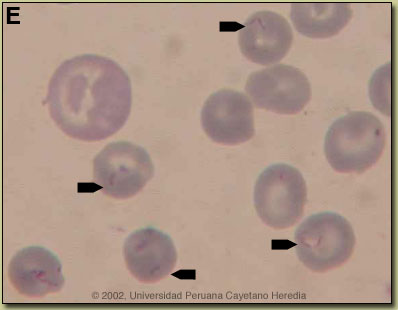
Image E for 03/23/07

| 2007 Case #8 |  |
|
| The following patient was seen in the inpatient department of the 36-bed Tropical Disease Unit at Cayetano Heredia National Hospital. |
|
History: 40-year-old male presented with a 25-day history of fever, chills, malaise, and headache. Two days after the onset of illness, the patient noticed scleral icterus and dark urine. The patient reports anorexia and a 5 kg weight loss. Epidemiology: Born and has lived for the past 6 months in the Department of La Libertad, 3150 meters above sea level. The patient owns a farm and raises hens, turkeys, guinea pigs, dogs, and cats. A cousin reportedly died 2 weeks earlier of a similar illness. Physical Examination: BP 110/60, HR 85, RR 24, T 37ºC. Mild respiratory distress. HEENT: scleral icterus. Pale conjuctiva. Lungs clear. 2/6 multifocal systolic murmur. Mild non-tender hepatomegaly. CNS: somnolent, not oriented in time. Glasgow coma scale=14. No meningeal signs. Laboratory Examination: Hematocrit 31, dropping to 22 on Day 2 of admission. Reticulocytes 2%. WBC 6.1, 54 neutrophils,17 monocytes,30 lymphs. Platelets 160,000. Creat 0.7, BUN 44. Total bilirubin 5.3, direct bilirubin 4.5. Alb 1.9 (low). AST 82, ALT 101 (2X normal). Alkaline phosphatase 169. LDH 1036 (high). CSF: WBC 40 (48% mononuclear). RBC 6,400. Protein 79 (N<45). Glucose 115. Chest X-ray [Day 4, Image A]. CT scan of the head [Image B] showed only mild edema. Blood film [Images C & D].  |
| Diagnosis: Acute bartonellosis due to Bartonella bacilliformis. |
|
Clinically the acute phase of infection follows an average 17-day incubation period. Almost all patients have fever, malaise, and anorexia. Pallor is usually noticeable, in hospitalized cases anyway, as the average admission hematocrit is 17%. The anemia is due to red-cell lysis and not autoimmune in nature as the Coombs test is uniformly negative. Hepatomegaly, lymphadenopathy, and jaundice each occur in about 3/4 of cases but splenomegaly in only about 1/4. A significant number of patients may develop congestive heart failure, pericardial effusion, or anasarca. Neurologic complications of uncertain etiology occur in about 20%; manifestations include altered mental status, ataxia, agitation, or even coma. Bartonella bacilliformis has only rarely been isolated in culture from these patients. Our patient had onset of respiratory distress on Day 2, and then a tonic-clonic seizure, decreased level of consciousness. Despite initiation of appropriate antibiotic therapy with ciprofloxacin and ceftriaxone immediately upon admission, progressive respiratory distress required mechanical ventilation and inotropic support in the ICU. On Day 9 the percentage of red cells with bacteria has decreased to 80%. Overall mortality of patients with neurologic manifestations is over 50% and altered mental status on hospital admission is correlated with mortality. A secondary immunosuppression may lead to subsequent or concomitant salmonellosis (both S. typhi and non typhi); toxoplasma reactivation and occasionally other opportunistic infections have been seen. No specific secondary agent has been isolated to date from this patient. In those untreated patients that have inapparent acute phases or survive the primary infection, a chronic eruptive phase occurs. Skin lesions, called Verruga Peruana, are most commonly miliary in nature with multiple 1-4 mm papular, erythematous round lesions that are often pruritic. These are loaded with bacteria and are histologically similar to HIV related bacillary angiomatosis lesions caused by the related organisms B. henselae and B. quintana. Bartonella henselae is also the agent of cat-scratch disease. The distribution of Bartonella bacilliformis, which is transmitted by the bite of the Lutzomyia verrucarum sandfly is restricted to the inter-Andean valleys of Peru and Ecuador. The railway between Lima and La Oroya high in the Andes was one of the engineering feats of the 19th century, but thousands of workers died of bartonellosis during construction (hence the name Oroya Fever). Classically, transmission was thought to be restricted to 500-2500 meters elevation and between 2-13 degrees latitude in these 2 countries, but more recently cases have been described up to 3200 meters. Travelers are more likely to encounter bartonellosis when trekking out of Huaraz in the Cordillera Blanca region of the country. Recent in vitro data confirm that B. bacilliformis is sensitive to most antibiotics including penicillins (including Penicillin G and ampicillin), cephalosporins, aminoglycosides, chloramphenicol, macrolides, tetracyclines, and quinolones [Antimicrob Agents Chemother. 2004 Jun;48(6):1921-33]. Ceftriaxone has the best MIC values of all antibiotics tested. In the past chloramphenicol has been used extensively in Peru because of its ability to simultaneously cover concomitant opportunistic salmonellosis. Because of increasing salmonella resistance to chloramphenicol and toxicity concerns with this drug, Ciprofloxacin 500 mg po bid for 10 days is now the first line therapy for uncomplicated cases, although clearly almost any available antibacterial agent will suffice for the bartonellosis itself. The bartonella and malaria endemic areas of Peru have little overlap. In a traveler to Peru with fever and anemia, the first diagnosis is malaria if they have been to low lying jungle regions but the first diagnosis should be bartonellosis if travel has been restricted to inter-Andean valleys. Untreated bartonellosis will almost always be fatal in a traveler. Antimalarials are not effective against bartonellosis. Always rule out malaria in a tropical traveler to endemic areas, but it is important not to let a patient with possible bartonellosis die for lack of a little ciprofloxacin or penicillin. Reference: Maguina C., et al. Bartonellosis (Carrion's Disease) in the Modern Era. Clin Infect Dis. 2001 Sep 15;33(6):772-9. |
Discussion: The blood film showed no malaria (altitude of residence is too high anyway) but overall >90% of the red blood cells contained small pleomorphic cocci intracellularly which are diagnostic of acute bartonellosis. Blood cultures using Columbia agar were drawn but must be incubated at 25-28°C and take up to 2-4 weeks to become positive. On average in bartonellosis, over 60% of erythrocytes have intracellular bacteria. These are most often coccobacilli [Image E, from
Discussion: The blood film showed no malaria (altitude of residence is too high anyway) but overall >90% of the red blood cells contained small pleomorphic cocci intracellularly which are diagnostic of acute bartonellosis. Blood cultures using Columbia agar were drawn but must be incubated at 25-28°C and take up to 2-4 weeks to become positive. On average in bartonellosis, over 60% of erythrocytes have intracellular bacteria. These are most often coccobacilli [Image E, from